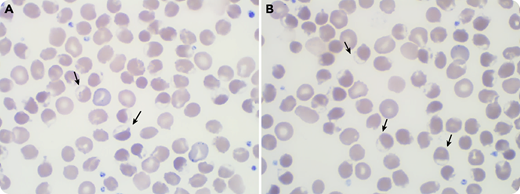
A 71-year-old white man was admitted for jaundice without fever or abdominal pain. He had received his last dose of durvalumab 2 months earlier for non–small cell lung cancer, and a first dose of anti–SARS-CoV-2 (severe acute respiratory syndrome coronavirus 2) vaccine a week earlier. The blood cell count revealed moderate anemia (120 g/L) with poikilocytosis and many bite cells (panels A-B; black arrows; original magnification ×100) on the peripheral blood smear. Within 48 hours, hemoglobin (Hb) had dropped to 48 g/L with a high reticulocyte count (250 × 109/L) and signs of hemolysis (hyperbilirubinemia: 208 µmol/L; lactate dehydrogenase: 983 U/L; haptoglobin: <0.01 g/L). Direct agglutination test (DAT) was negative. He was admitted in the intensive care unit for aspiration pneumonia, acute renal failure, and altered mental status. After a massive red blood cell infusion, the evolution was favorable. He was diagnosed with glucose-6-phosphate dehydrogenase (G6PD) deficiency with a very low G6PD rate: 0.8 UI/g Hb (reference: 11-17 UI/g).

A 71-year-old white man was admitted for jaundice without fever or abdominal pain. He had received his last dose of durvalumab 2 months earlier for non–small cell lung cancer, and a first dose of anti–SARS-CoV-2 (severe acute respiratory syndrome coronavirus 2) vaccine a week earlier. The blood cell count revealed moderate anemia (120 g/L) with poikilocytosis and many bite cells (panels A-B; black arrows; original magnification ×100) on the peripheral blood smear. Within 48 hours, hemoglobin (Hb) had dropped to 48 g/L with a high reticulocyte count (250 × 109/L) and signs of hemolysis (hyperbilirubinemia: 208 µmol/L; lactate dehydrogenase: 983 U/L; haptoglobin: <0.01 g/L). Direct agglutination test (DAT) was negative. He was admitted in the intensive care unit for aspiration pneumonia, acute renal failure, and altered mental status. After a massive red blood cell infusion, the evolution was favorable. He was diagnosed with glucose-6-phosphate dehydrogenase (G6PD) deficiency with a very low G6PD rate: 0.8 UI/g Hb (reference: 11-17 UI/g).
The vaccine was first incriminated, but careful examination revealed fava bean ingestion the day before the onset of the symptoms, typically causing Hb oxidation and triggering hemolysis in the case of G6PD deficiency. He had never experienced similar symptoms. There was likely no relation between the COVID-19 vaccine or durvalumab and G6PD deficiency. This case emphasizes the cornerstone role of cytology in G6PD-deficiency diagnosis even before the onset of anemia.
A 71-year-old white man was admitted for jaundice without fever or abdominal pain. He had received his last dose of durvalumab 2 months earlier for non–small cell lung cancer, and a first dose of anti–SARS-CoV-2 (severe acute respiratory syndrome coronavirus 2) vaccine a week earlier. The blood cell count revealed moderate anemia (120 g/L) with poikilocytosis and many bite cells (panels A-B; black arrows; original magnification ×100) on the peripheral blood smear. Within 48 hours, hemoglobin (Hb) had dropped to 48 g/L with a high reticulocyte count (250 × 109/L) and signs of hemolysis (hyperbilirubinemia: 208 µmol/L; lactate dehydrogenase: 983 U/L; haptoglobin: <0.01 g/L). Direct agglutination test (DAT) was negative. He was admitted in the intensive care unit for aspiration pneumonia, acute renal failure, and altered mental status. After a massive red blood cell infusion, the evolution was favorable. He was diagnosed with glucose-6-phosphate dehydrogenase (G6PD) deficiency with a very low G6PD rate: 0.8 UI/g Hb (reference: 11-17 UI/g).
The vaccine was first incriminated, but careful examination revealed fava bean ingestion the day before the onset of the symptoms, typically causing Hb oxidation and triggering hemolysis in the case of G6PD deficiency. He had never experienced similar symptoms. There was likely no relation between the COVID-19 vaccine or durvalumab and G6PD deficiency. This case emphasizes the cornerstone role of cytology in G6PD-deficiency diagnosis even before the onset of anemia.
For additional images, visit the ASH Image Bank, a reference and teaching tool that is continually updated with new atlas and case study images. For more information, visit http://imagebank.hematology.org.